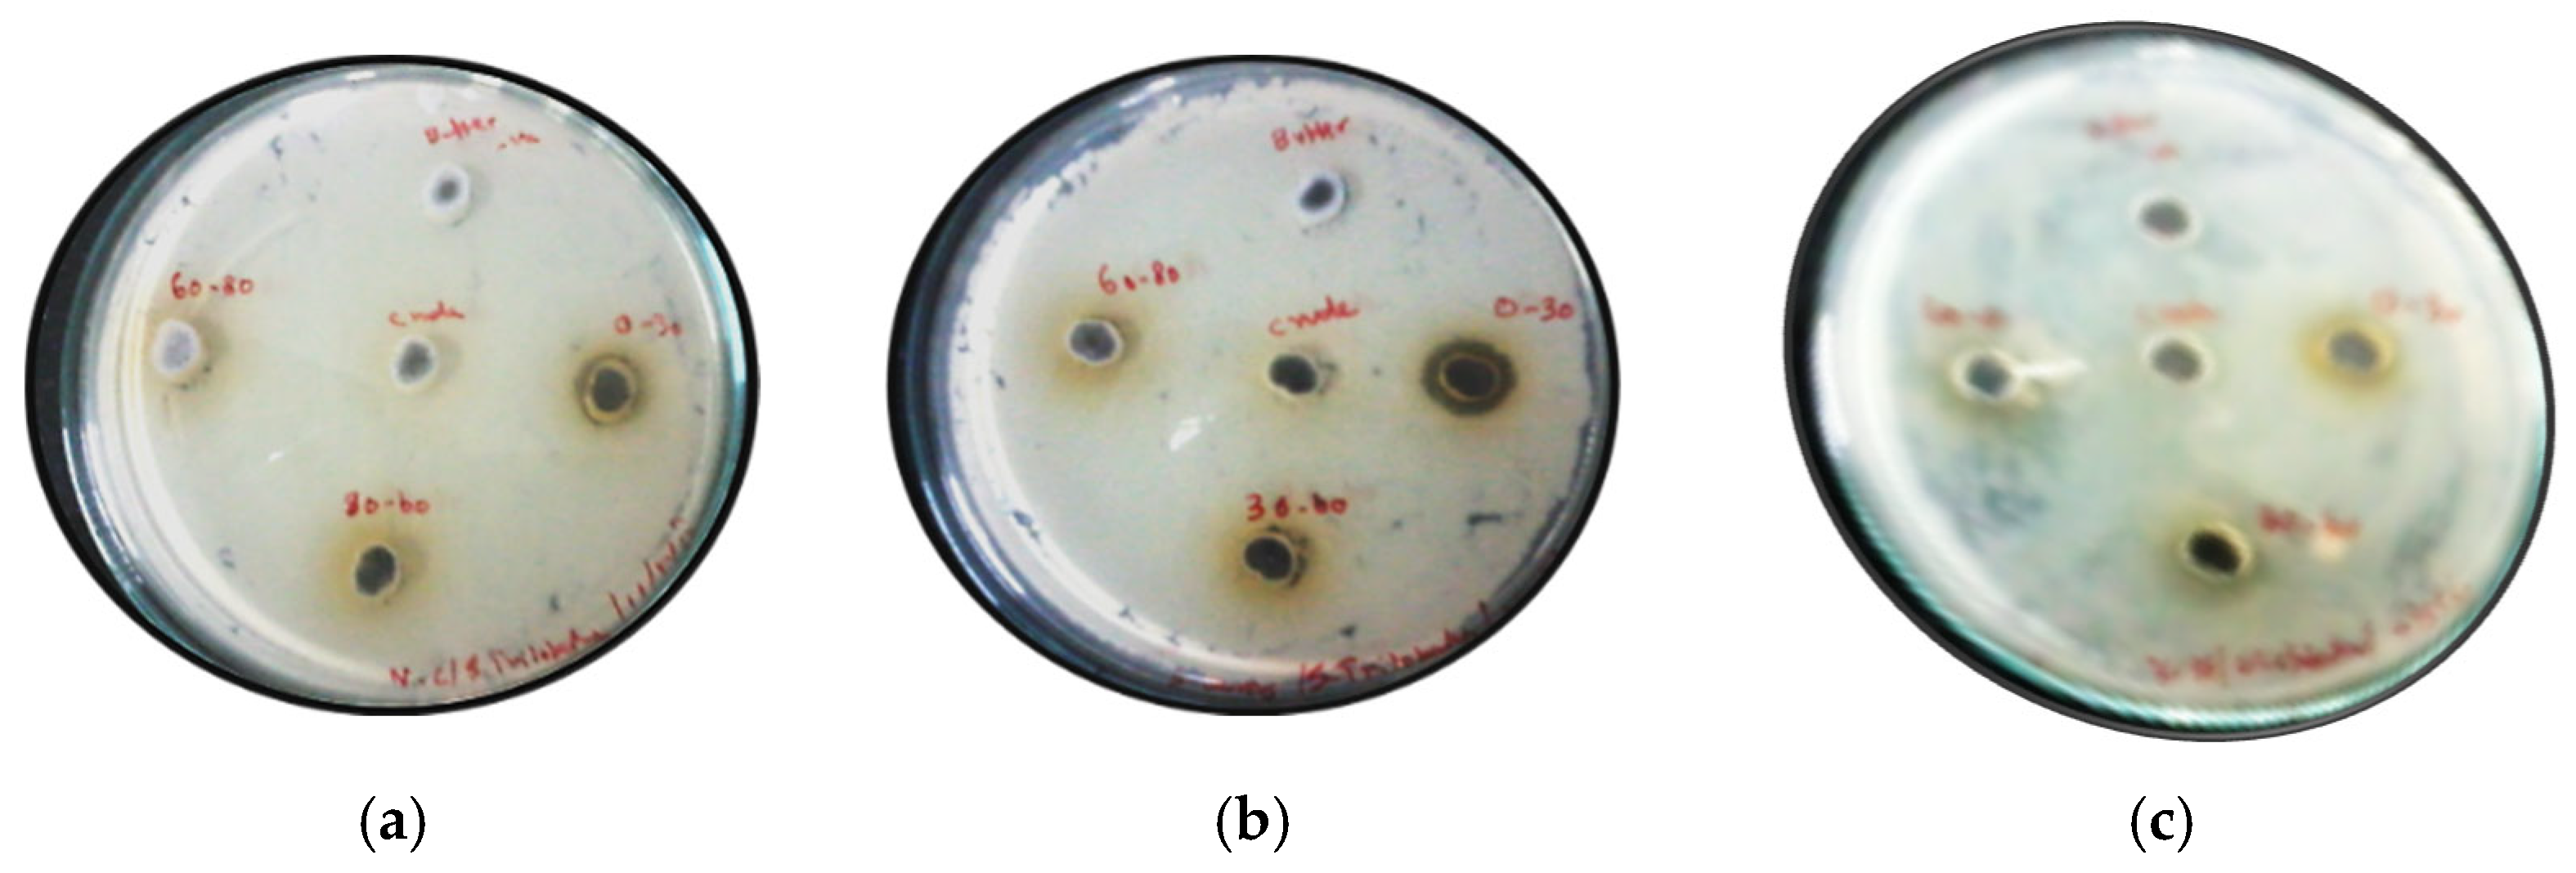

Leucine-Rich, Potent Anti-Bacterial Protein against Vibrio cholerae, Staphylococcus aureus from Solanum trilobatum Leaves
Abstract
:1. Introduction
2. Results and Discussion
2.1. Ammonium Sulfate Fractions of Solanum trilobatum Leaves Are Rich in Antibacterial Action
2.2. Ion Exchange Chromatography of Solanum trilobatum Active Fraction
2.3. The Antibacterial Protein Isolated from the Leaves of Solanum trilobatum Is a Leucine-Rich Luminal Binding Protein (LBP)
2.4. LBP Is Majorly Composed of α Helix
2.5. Molecular Modelling of LBP
2.6. LBP Treatment Imparts Characteristic Morphological Changes in V. cholerae and S. aureus
2.7. LBP Had Agglutination on Rat RBCs
2.8. LBP Binds to Sugars Such as Trehalose, Mannose, Raffinose and Sorbitol
3. Materials and Methods
3.1. Bacterial Cultures and Reagents Used in Present Study
3.2. Extraction of Principle Isolate from Solanum trilobatum
3.3. Antibacterial Assay by Well Diffusion Method
3.4. Purification of Antibacterial Protein by Ion-Exchange Chromatography
3.5. Minimal Inhibitory Concentration (MIC) by Micro Dilution Assay
3.6. Mass Spectrometry—Peptide Mass Fingerprinting
3.7. Circular Dichroism Measurements to Analyze the Secondary Structural Content of STAP
3.8. Homology Modelling of S
3.9. Scanning Electron Microscope (SEM) Studies on STAP
3.10. Hemagglutination Assay
Alsever’s Solution
3.11. Hemagglutination-Inhibition Assays
Carbohydrates Binding Specificity of LBP
4. Conclusions
Supplementary Materials
Author Contributions
Funding
Institutional Review Board Statement
Informed Consent Statement
Data Availability Statement
Conflicts of Interest
Sample Availability
References
- Choi, K.-Y.; Chow, L.N.; Mookherjee, N. Cationic host defence peptides: Multifaceted role in immune modulation and inflammation. J. Innate Immun. 2012, 4, 361–370. [Google Scholar] [CrossRef]
- Yount, N.Y.; Yeaman, M.R. Peptide antimicrobials: Cell wall as a bacterial target. Ann. N. Y. Acad. Sci. 2013, 1277, 127–138. [Google Scholar] [CrossRef] [PubMed]
- Gonzalez-Lamothe, R.; Mitchell, G.; Gattuso, M.; Diarra, M.S.; Malouin, F.; Boouarab, K. Plant antimicrobial agents and their effects on plant and human pathogens. Int. J. Mol. Sci. 2009, 10, 3400–3419. [Google Scholar] [CrossRef] [PubMed]
- Feng, J.; Yuan, F.; Gao, Y.; Liang, C.; Xu, J.; Zhang, C.; He, L. A novel antimicrobial protein isolated from potato (Solanum tuberosum) shares homology with an acid phosphatase. Biochem. J. 2003, 376 Pt 2, 481–487. [Google Scholar] [CrossRef] [PubMed] [Green Version]
- Chowdhury, N.; Laskar, S.; Chandra, G. Mosquito larvicidal and antimicrobial activity of protein of Solanum villosum leaves. BMC Complement. Altern. Med. 2008, 8, 62. [Google Scholar] [CrossRef] [Green Version]
- Campos, M.L.; de Souza, C.M.; de Oliveira, K.B.S.; Dias, S.C.; Franco, O.L. The role of antimicrobial peptides in plant immunity. J. Exp. Bot. 2018, 69, 4997–5011. [Google Scholar] [CrossRef] [Green Version]
- Pelegrini, P.B.; Del Sarto, R.P.; Silva, O.N.; Franco, O.L.; Grossi-De-Sa, M.F. Antibacterial peptides from plants: What they are and how they probably work. Biochem. Res. Int. 2011, 2011, 250349. [Google Scholar] [CrossRef] [Green Version]
- Manohar, R.; Kutumbarao, N.H.V.; Nagampalli, R.S.K.; Velmurugan, D.; Gunasekaran, K. Structural insights and binding of a natural ligand, succinic acid with serine and cysteine proteases. Biochem. Biophys. Res. Commun. 2018, 495, 679–685. [Google Scholar] [CrossRef]
- Emmanuel, S.; Ignacimuthu, S.; Perumalsamy, R.; Amalraj, T. Antiinflammatory activity of Solanum trilobatum. Fitoterapia 2006, 77, 611–612. [Google Scholar] [CrossRef] [PubMed]
- Govindan, S.; Viswanathan, S.; Vijayasekaran, V.; Alagappan, R. A pilot study on the clinical efficacy of Solanum xanthocarpum and Solanum trilobatum in bronchial asthma. J. Ethnopharmacol. 1999, 66, 205–210. [Google Scholar] [CrossRef]
- Balu, S.; Madhavan, S.; Babu, T. Effect of foliar fertilisation on growth of Solanum trilobatum L. Anc. Sci. Life. 1996, 15, 172–175. [Google Scholar] [PubMed]
- Mohanan, P.V.; Devi, K.S. Cytotoxic potential of the preparations from Solanum trilobatum and the effect of sobatum on tumour reduction in mice. Cancer Lett. 1996, 110, 71–76. [Google Scholar] [CrossRef]
- Shahjahan, M.; Sabitha, K.E.; Jainu, M.; Devi, C.S.S. Effect of Solanum trilobatum against carbon tetrachloride induced hepatic damage in albino rats. Indian J. Med. Res. 2004, 120, 194–198. [Google Scholar]
- Doss, A. Preliminary phytochemical screening of some Indian Medicinal Plants. Anc. Sci. Life 2009, 29, 12–16. [Google Scholar]
- Shahjahan, M.; Vani, G.; Shyamaladevi, C.S. Effect of Solanum trilobatum on the antioxidant status during diethyl nitrosamine induced and phenobarbital promoted hepatocarcinogenesis in rat. Chem. Biol. Interact. 2005, 156, 113–123. [Google Scholar] [CrossRef] [PubMed]
- Rajkumar, S.; Jebanesan, A. Oviposition deterrent and skin repellent activities of Solanum trilobatum leaf extract against the malarial vector Anopheles stephensi. J. Insect Sci. 2005, 5, 15. [Google Scholar] [CrossRef] [PubMed]
- Jenkins, A.; Diep, B.A.; May, T.T.; Vo, N.H.; Warrener, P.; Suzich, J.; Stover, C.K.; Sellman, B.R. Differential expression and roles of Staphylococcus aureus virulence determinants during colonization and disease. mBio 2015, 6, e02272-14. [Google Scholar] [CrossRef] [Green Version]
- Faruque, S.M.; Albert, M.J.; Mekalanos, J.J. Epidemiology, genetics, and ecology of toxigenic Vibrio cholerae. Microbiol. Mol. Biol. Rev. 1998, 62, 1301–1314. [Google Scholar] [CrossRef] [Green Version]
- Laemmli, U.K. Cleavage of structural proteins during the assembly of the head of bacteriophage T4. Nature 1970, 227, 680–685. [Google Scholar] [CrossRef]
- Alvim, F.C.; Carolino, S.M.B.; Cascardo, J.C.M.; Nunes, C.C.; Martinez, C.A.; Otoni, W.C.; Fontes, E.P.B. Enhanced accumulation of BiP in transgenic plants confers tolerance to water stress. Plant Physiol. 2001, 126, 1042–1054. [Google Scholar] [CrossRef] [Green Version]
- Ma, Y.; Hendershot, L.M. ER chaperone functions during normal and stress conditions. J. Chem. Neuroanat. 2004, 28, 51–65. [Google Scholar] [CrossRef] [PubMed]
- Malhotra, J.D.; Kaufman, R.J. The endoplasmic reticulum and the unfolded protein response. Semin. Cell Dev. Biol. 2007, 18, 716–731. [Google Scholar] [CrossRef] [PubMed] [Green Version]
- Morris, J.A.; Dorner, A.J.; Edwards, C.A.; Hendershot, L.M.; Kaufman, R.J. Immunoglobulin binding protein (BiP) function is required to protect cells from endoplasmic reticulum stress but is not required for the secretion of selective proteins. J. Biol. Chem. 1997, 272, 4327–4334. [Google Scholar] [CrossRef] [Green Version]
- Leborgne-Castel, N.; Jelitto-Van Sooren, E.P.; Crofts, A.J.; Denecke, J. Overexpression of BiP in tobacco alleviates endoplasmic reticulum stress. Plant Cell 1999, 11, 459–469. [Google Scholar] [CrossRef] [PubMed] [Green Version]
- Park, C.-J.; Song, M.-Y.; Kim, C.-Y.; Jeon, J.-S.; Ronald, P.C. Rice BiP3 regulates immunity mediated by the PRRs XA3 and XA21 but not immunity mediated by the NB-LRR protein, Pi5. Biochem. Biophys. Res. Commun. 2014, 448, 70–75. [Google Scholar] [CrossRef]
- Zhang, Z.; Thomma, B.P. Structure-function aspects of extracellular leucine-rich repeat-containing cell surface receptors in plants. J. Integr. Plant Biol. 2013, 55, 1212–1223. [Google Scholar] [CrossRef] [PubMed]
- Batista, A.B.; Oliveira, J.T.A.; Gifoni, J.M.; Pereira, M.L.; Almeida, M.G.G.; Gomes, V.M.; Da Cunha, M.; Ribeiro, S.F.F.; Dias, G.B.; Beltramini, L.M.; et al. New insights into the structure and mode of action of Mo-CBP3, an antifungal chitin-binding protein of Moringa oleifera seeds. PLoS ONE 2014, 9, e111427. [Google Scholar] [CrossRef] [PubMed]
- Shin, S.Y.; Kang, J.H.; Hahm, K.S. Structure-antibacterial, antitumor and hemolytic activity relationships of cecropin A-magainin 2 and cecropin A-melittin hybrid peptides. J. Pept. Res. 1999, 53, 82–90. [Google Scholar] [CrossRef]
- Dathe, M.; Wieprecht, T. Structural features of helical antimicrobial peptides: Their potential to modulate activity on model membranes and biological cells. Biochim. Biophys. Acta 1999, 1462, 71–87. [Google Scholar] [CrossRef] [Green Version]
- Perez-Iratxeta, C.; Andrade-Navarro, M.A. K2D2: Estimation of protein secondary structure from circular dichroism spectra. BMC Struct. Biol. 2008, 8, 1–5. [Google Scholar] [CrossRef] [Green Version]
- Ebran, N.; Julien, S.; Orange, N.; Saglio, P.; Lemaitre, C.; Molle, G. Pore-forming properties and antibacterial activity of proteins extracted from epidermal mucus of fish. Comp. Biochem. Physiol. Part A Mol. Integr. Physiol. 1999, 122, 181–189. [Google Scholar] [CrossRef]
- Panchal, R.; Smart, M.L.; Bowsed, D.N.; Williams, D.A.; Petrou, S. Pore-forming proteins and their application in biotechnology. Curr. Pharm. Biotechnol. 2002, 3, 99–115. [Google Scholar] [CrossRef] [PubMed]
- Page, M.I. The mechanisms of reactions of beta-lactam antibiotics. Acc. Chem. Res. 1984, 17, 144–151. [Google Scholar] [CrossRef]
- Caroff, M.; Karibian, D. Structure of bacterial lipopolysaccharides. Carbohydr. Res. 2003, 338, 2431–2447. [Google Scholar] [CrossRef] [PubMed]
- Zentella, R.; Mascorro-Gallardo, J.O.; Van Dijck, P.; Folch-Mallol, J.; Bonini, B.; Van Vaeck, C.; Gaxiola, R.; Covarrubias, A.A.; Nieto-Sotelo, J.; Thevelein, J.M.; et al. A Selaginella lepidophylla trehalose-6-phosphate synthase complements growth and stress-tolerance defects in a yeast tps1 mutant. Plant Physiol. 1999, 119, 1473–1482. [Google Scholar] [CrossRef] [Green Version]
- Wingfield, P. Protein precipitation using ammonium sulfate. Curr. Protoc. Protein Sci. 1998, 13, A. 3F. 1–A. 3F. 8. [Google Scholar]
- Allen, K.L.; Molan, P.C.; Reid, G.M. A Survey of the Antibacterial Activity of Some New Zealand Honeys. J. Pharm. Pharmacol. 2011, 43, 817–822. [Google Scholar] [CrossRef]
- Jungbauer, A.; Hahn, R. Ion-exchange chromatography. Methods Enzymol. 2009, 463, 349–371. [Google Scholar]
- Fuchs, P.C.; Barry, A.L.; Brown, S.D. In vitro antimicrobial activity of MSI-78, a magainin analog. Antimicrob. Agents Chemother. 1998, 42, 1213–1216. [Google Scholar] [CrossRef] [Green Version]
- Andrews, J.M. Determination of minimum inhibitory concentrations. J. Antimicrob. Chemother. 2001, 48 (Suppl. 1), 5–16. [Google Scholar] [CrossRef] [Green Version]
- Jensen, O.N.; Podtelejnikov, A.; Mann, M. Delayed extraction improves specificity in database searches by matrix-assisted laser desorption/ionization peptide maps. Rapid Commun. Mass Spectrom. 1996, 10, 1371–1378. [Google Scholar] [CrossRef]
- Williams, K.R.; Stone, K.L. In gel digestion of SDS PAGE-separated proteins: Observations from internal sequencing of 25 proteins. Tech. Protein Chem. 1995, 6, 143–152. [Google Scholar]
- Whitmore, L.; Wallace, B.A. Protein secondary structure analyses from circular dichroism spectroscopy: Methods and reference databases. Biopolym. Orig. Res. Biomol. 2008, 89, 392–400. [Google Scholar] [CrossRef] [PubMed]
- Boeckmann, B.; Bairoch, A.; Apweiler, R.; Blatter, M.-C.; Estreicher, A.; Gasteiger, E.; Martin, M.J.; Michoud, K.; O’Donovan, C.; Phan, I.; et al. The SWISS-PROT protein knowledgebase and its supplement TrEMBL in 2003. Nucleic Acids Res. 2003, 31, 365–370. [Google Scholar] [CrossRef]
- Yang, J.; Yan, R.; Roy, A.; Xu, D.; Poisson, J.; Zhang, Y. The I-TASSER Suite: Protein structure and function prediction. Nat. Methods 2015, 12, 7–8. [Google Scholar] [CrossRef] [PubMed] [Green Version]
- De Lano, W.L. The PyMOL Molecular Graphics System; DeLano Scientific: San Carlos, CA, USA, 2002. [Google Scholar]
- Hartmann, M.; Berditsch, M.; Hawecker, J.; Ardakani, M.F.; Gerthsen, D.; Ulrich, A.S. Damage of the bacterial cell envelope by antimicrobial peptides gramicidin S and PGLa as revealed by transmission and scanning electron microscopy. Antimicrob. Agents Chemother. 2010, 54, 3132–3142. [Google Scholar] [CrossRef] [PubMed] [Green Version]
- Johnson, H.M.; Brenner, K.; Angelotti, R.; Hall, H.E. Serological studies of types A, B, and E botulinal toxins by passive hemagglutination and bentonite flocculation. J. Bacteriol. 1966, 91, 967–974. [Google Scholar] [CrossRef] [Green Version]
- Bukantz, S.C.; Rein, C.R.; Kent, J.F. Studies in complement fixation; preservation of sheep’s blood in citrate dextrose mixtures (modified Alsever’s solution) for use in the complement fixation reaction. J. Lab. Clin. Med. 1946, 31, 394–399. [Google Scholar]
- Garvey, J.; Cremer, N.; Sussdorf, D. Methods in Immunology; WA Benjamin Inc.: Reading, MA, USA, 1979; p. 545. [Google Scholar]
- Johnson, H.M.; Brenner, K.; Hall, H.E. The use of a wate-soluble carbodiimide as a coupling reagent in the passive hemagglutination test. J. Immunol. 1966, 97, 791–796. [Google Scholar]

| Tested Strain | Different Protein Concentrations Tested (1 mg/mL) | |||||||||
|---|---|---|---|---|---|---|---|---|---|---|
| 10 μL | 20 μL | 30 μL | 40 μL | 50 μL | 60 μL | 70 μL | 80 μL | 90 μL | 100 μL | |
| S. aureus | + | + | − | − | − | − | − | − | − | − |
| V.cholerae | + | + | − | − | − | − | − | − | − | − |
| Negative Control | + | + | + | + | + | + | + | + | + | + |
| Positive Control | − | − | − | − | − | − | − | − | − | − |
| No. of Fragments | Observed | Mr Expt | Obtained Fragments |
|---|---|---|---|
| 2–10 | 1066.6100 | 1065.6027 | IPKVQQLLK |
| 2–16 | 1791.9340 | 1790.9267 | IPKVQQLLKDYFDGK |
| 49–71 | 2384.2130 | 1790.9267 | DILLLDVAPLTLGIETVGGVMTK |
| 72–83 | 1365.7900 | 1364.7827 | LIPRNTVIPSKK |
| 84–106 | 2705.4460 | 2704.4387 | SQVFTTYQDQQTTVTIQVFEGER |
| 118–128 | 1157.7100 | 1156.7027 | FDLTGIAPAPR |
| 177–189 | 1554.8060 | 1553.7987 | MVKEAEEFAEEDK |
Publisher’s Note: MDPI stays neutral with regard to jurisdictional claims in published maps and institutional affiliations. |
© 2022 by the authors. Licensee MDPI, Basel, Switzerland. This article is an open access article distributed under the terms and conditions of the Creative Commons Attribution (CC BY) license (https://creativecommons.org/licenses/by/4.0/).
Share and Cite
Radhakrishnan, M.; Palayam, M.; Altemimi, A.B.; Karthik, L.; Krishnasamy, G.; Cacciola, F.; Govindan, L. Leucine-Rich, Potent Anti-Bacterial Protein against Vibrio cholerae, Staphylococcus aureus from Solanum trilobatum Leaves. Molecules 2022, 27, 1167. https://doi.org/10.3390/molecules27041167
Radhakrishnan M, Palayam M, Altemimi AB, Karthik L, Krishnasamy G, Cacciola F, Govindan L. Leucine-Rich, Potent Anti-Bacterial Protein against Vibrio cholerae, Staphylococcus aureus from Solanum trilobatum Leaves. Molecules. 2022; 27(4):1167. https://doi.org/10.3390/molecules27041167
Chicago/Turabian StyleRadhakrishnan, Manohar, Malathy Palayam, Ammar B. Altemimi, Lakshminarayanan Karthik, Gunasekaran Krishnasamy, Francesco Cacciola, and Lakshmanan Govindan. 2022. "Leucine-Rich, Potent Anti-Bacterial Protein against Vibrio cholerae, Staphylococcus aureus from Solanum trilobatum Leaves" Molecules 27, no. 4: 1167. https://doi.org/10.3390/molecules27041167
APA StyleRadhakrishnan, M., Palayam, M., Altemimi, A. B., Karthik, L., Krishnasamy, G., Cacciola, F., & Govindan, L. (2022). Leucine-Rich, Potent Anti-Bacterial Protein against Vibrio cholerae, Staphylococcus aureus from Solanum trilobatum Leaves. Molecules, 27(4), 1167. https://doi.org/10.3390/molecules27041167

